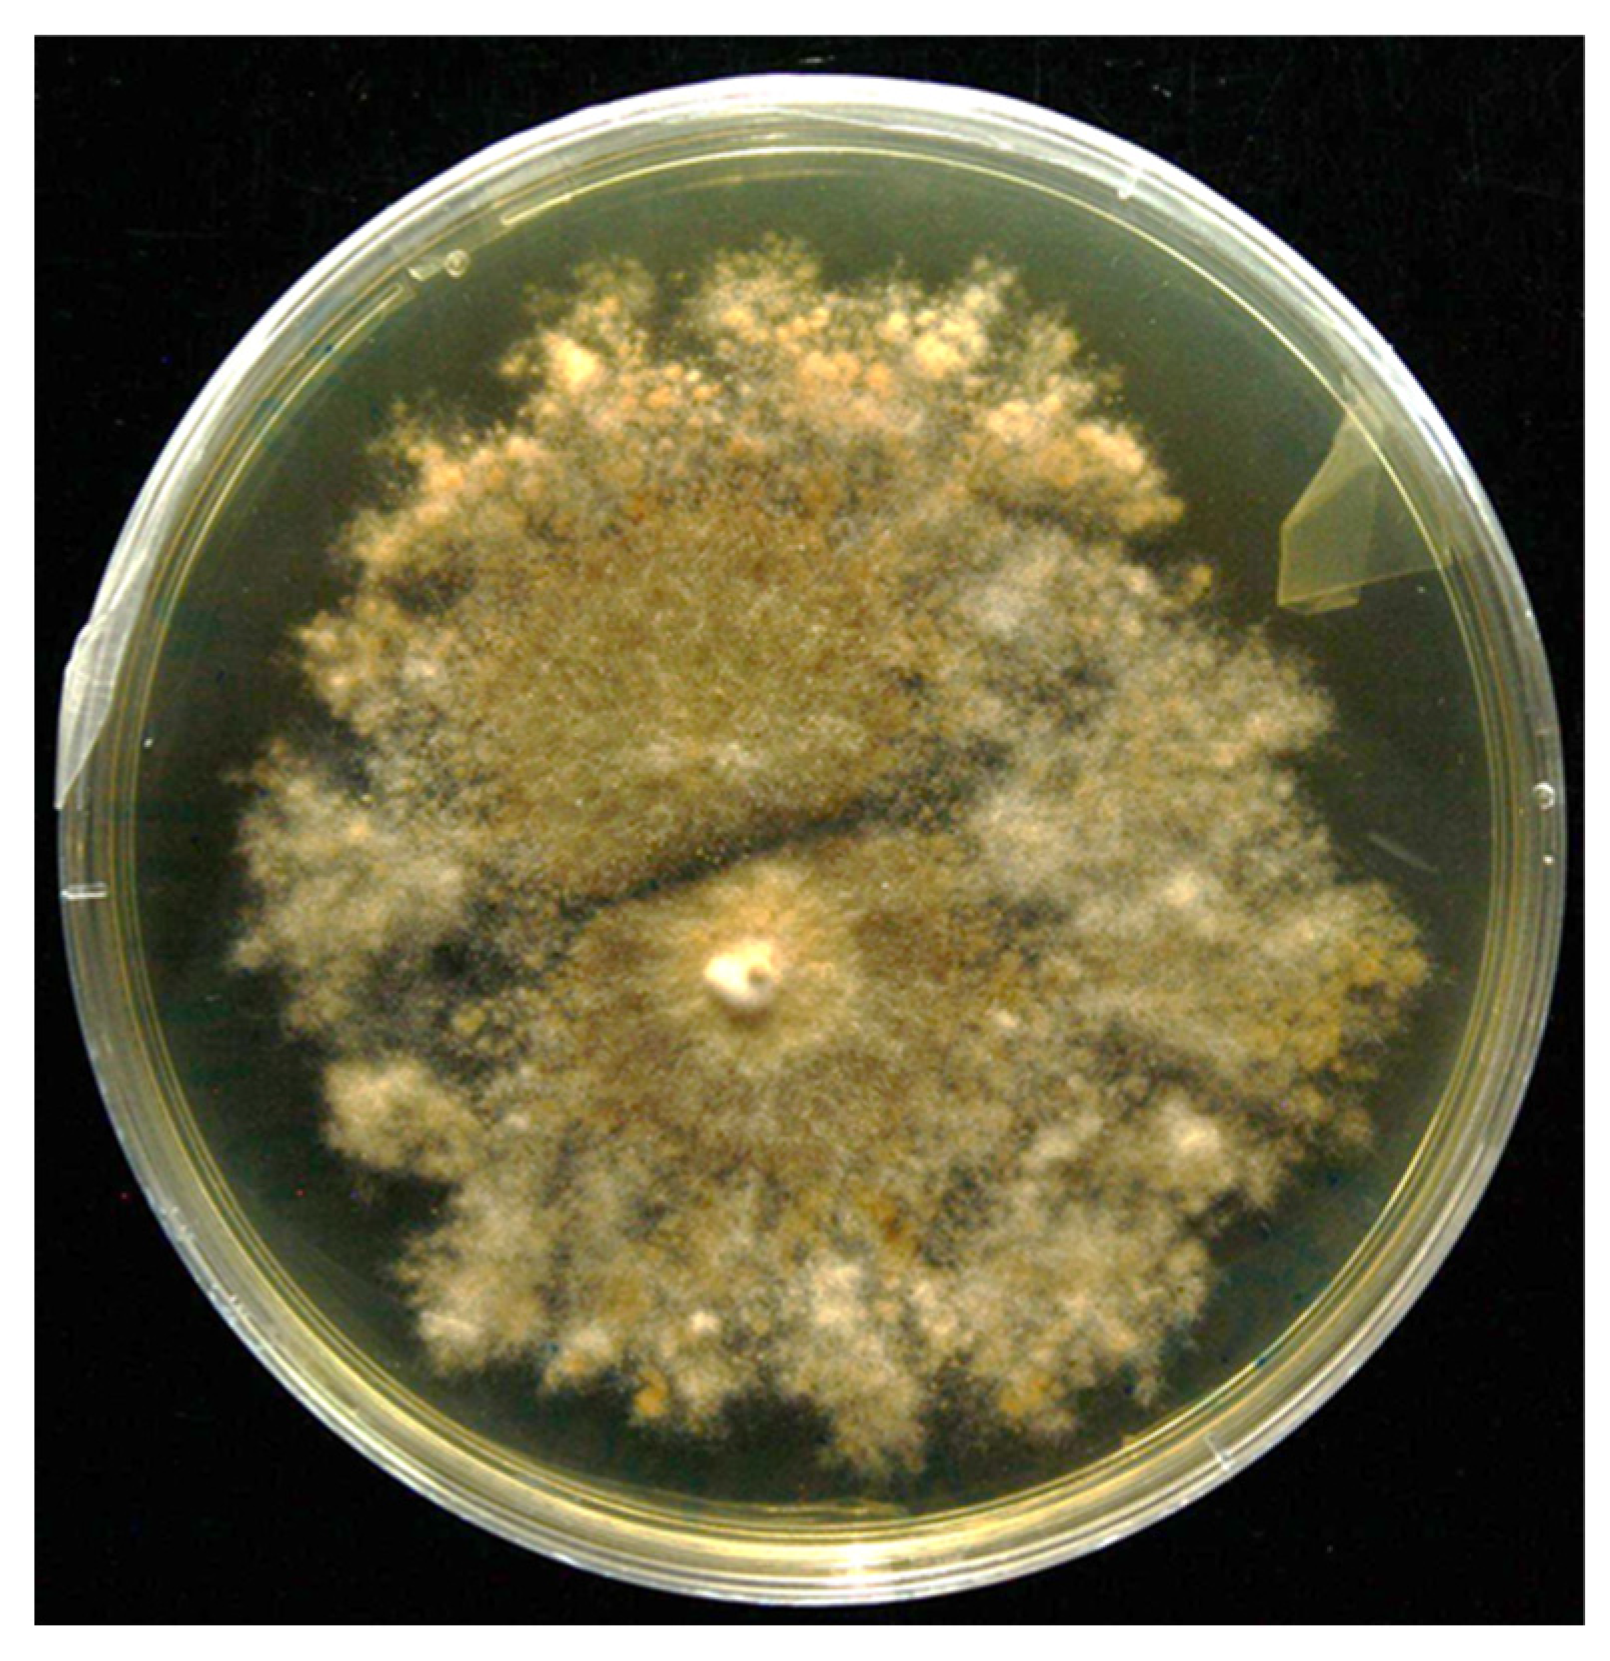
Microorganisms 13 01123 g003

Jet-Breaking Extrusion of Alginate–Chitosan Capsules for Encapsulation of Plant Growth–Promoting Extremophilic Fungi
Abstract
1. Introduction
2. Materials and Methods
2.1. Chemicals
2.2. Isolation and Molecular Identification of Extremophilic Endophyte Root-Associated Fungus
2.3. Characterization of Extremophilic Root-Associated Fungus
2.4. Preparation of Encapsulating and Core Solutions
2.5. Preparation of Fungi Alginate–Chitosan Capsules by Jet Breaking Extrusion
2.6. Sphericity and Mean Size of Capsules
2.7. Morphology
2.8. Survival of Encapsulated Fungus
2.9. Statistical Analysis
3. Results
3.1. Isolation and Screening of PGP Traits and Hydrolytic Enzyme Activities
3.2. Formulation of Alginate–Chitosan Capsules Containing P. nalgiovense
3.3. Morphological Analysis of Alginate–Chitosan Capsules
3.4. Viability of Encapsulated Fungus
4. Discussion
5. Conclusions
Author Contributions
Funding
Institutional Review Board Statement
Informed Consent Statement
Data Availability Statement
Acknowledgments
Conflicts of Interest
References
- Bilal, S.; Shahzad, R.; Imran, M.; Jan, R.; Kim, K.M.; Lee, I.J. Synergistic association of endophytic fungi enhances Glycine max L. resilience to combined abiotic stresses: Heavy metals, high temperature and drought stress. Ind. Crops Prod. 2020, 143, 111931. [Google Scholar] [CrossRef]
- Tiwari, P.; Bose, S.K.; Park, K.-I.; Dufossé, L.; Fouillaud, M. Plant-microbe interactions under the extreme habitats and their potential applications. Microorganisms 2024, 12, 448. [Google Scholar] [CrossRef] [PubMed]
- Yarzábal Rodríguez, L.A.; Álvarez Gutiérrez, P.E.; Gunde-Cimerman, N.; Ciancas Jiménez, J.C.; Gutiérrez-Cepeda, A.; Ocaña, A.M.F.; Batista-García, R.A. Exploring extremophilic fungi in soil mycobiome for sustainable agriculture amid global change. Nat. Commun. 2024, 15, 6951. [Google Scholar] [CrossRef] [PubMed]
- Yooyongwech, S.; Suriyan, C.-U.; Tisarum, R.; Therawitaya, C.; Samphumphung, T.; Aumtong, S.; Kingkaew, J.; Phisalaphong, M.J. Influence of different encapsulation types of arbuscular mycorrhizal fungi on physiological adaptation and growth promotion of maize (Zea mays L.) subjected to water deficit. Not. Bot. Horti Agrobot. 2019, 47, 213–220. [Google Scholar] [CrossRef]
- Barnes, C.J.; van der Gast, C.J.; McNamara, N.P.; Rowe, R.; Bending, G. Extreme rainfall affects assembly of the root-associated fungal community. New Phytol. 2018, 220, 1172–1184. [Google Scholar] [CrossRef]
- Abd-Elsalam, K.A.; Hashim, A.F.; Abdelkhalek, T.E.; Hassan, R.K. Encapsulation of Soil Nutrients for Plant Growth and Development. In Biopolymeric Nanoparticles for Agricultural Applications; Springer: Cham, Switzerland, 2024; pp. 145–174. [Google Scholar] [CrossRef]
- Klein, S.; Kuhn, J.; Avrahami, R.; Tarre, S.; Beliavski, M.; Green, M.; Zussman, E. Encapsulation of bacterial cells in electrospun microtubes. Biomacromolecules 2009, 10, 1751–1756. [Google Scholar] [CrossRef]
- Schoebitz, M.; López, M.D.; Roldán, A.J. Bioencapsulation of microbial inoculants for better soil–plant fertilization. A review. Agron. Sustain. Dev. 2013, 33, 751–765. [Google Scholar] [CrossRef]
- Kim, C.; Chung, S.; Kim, Y.E.; Lee, K.S.; Lee, S.H.; Oh, K.W.; Kang, J.Y. Generation of core-shell microcapsules with three-dimensional focusing device for efficient formation of cell spheroid. Lab Chip 2011, 11, 246–252. [Google Scholar] [CrossRef]
- Valdivia-Rivera, S.; Ayora-Talavera, T.; Lizardi-Jiménez, M.A.; García-Cruz, U.; Cuevas-Bernardino, J.C.; Pacheco, N.J. Encapsulation of microorganisms for bioremediation: Techniques and carriers. Rev. Environ. Sci. Biotechnol. 2021, 20, 815–838. [Google Scholar] [CrossRef]
- De Jaeger, N.; De la Providencia, I.; Rouhier, H.; Declerck, S.J. Co-entrapment of Trichoderma harzianum and Glomus sp. within alginate beads: Impact on the arbuscular mycorrhizal fungi life cycle. J. Appl. Microbiol. 2011, 111, 125–135. [Google Scholar] [CrossRef]
- Bennacef, C.; Desobry-Banon, S.; Linder, M.; Khanji, A.N.; Probst, L.; Desobry, S. Study and optimization of core-shell capsules produced by annular jet breaking coextrusion. Coll. Surf. A Physicochem. Eng. Asp. 2021, 629, 127475. [Google Scholar] [CrossRef]
- Wu, Q.; Zhang, T.; Xue, Y.; Xue, C.; Wang, Y. Preparation of alginate core–shell beads with different M/G ratios to improve the stability of fish oil. LWT-Food Sci. Technol. 2017, 80, 304–310. [Google Scholar] [CrossRef]
- Messaoud, G.B.; Sánchez-González, L.; Probst, L.; Desobry, S. Influence of internal composition on physicochemical properties of alginate aqueous-core capsules. J. Colloid Interface Sci. 2016, 469, 120–128. [Google Scholar] [CrossRef] [PubMed]
- Tan, L.H.; Chan, L.W.; Heng, P. Alginate/starch composites as wall material to achieve microencapsulation with high oil loading. J. Microencapsul. 2009, 26, 263–271. [Google Scholar] [CrossRef]
- Peniche, C.; Argüelles-Monal, W.; Peniche, H.; Acosta, N. Chitosan: An attractive biocompatible polymer for microencapsulation. Macromol. Biosci. 2003, 3, 511–520. [Google Scholar] [CrossRef]
- Dziadek, M.; Dziadek, K.; Salagierski, S.; Drozdowska, M.; Serafim, A.; Stancu, I.-C.; Szatkowski, P.; Kopec, A.; Rajzer, I.; Douglas, T. Newly crosslinked chitosan-and chitosan-pectin-based hydrogels with high antioxidant and potential anticancer activity. Carbohydr. Polym. 2022, 290, 119486. [Google Scholar] [CrossRef]
- LogithKumar, R.; KeshavNarayan, A.; Dhivya, S.; Chawla, A.; Saravanan, S.; Selvamurugan, N. A review of chitosan and its derivatives in bone tissue engineering. Carbohydr. Polym. 2016, 151, 172–188. [Google Scholar] [CrossRef]
- Luo, Y.; Wang, Q. Recent development of chitosan-based polyelectrolyte complexes with natural polysaccharides for drug delivery. Int. J. Biol. Macromol. 2014, 64, 353–367. [Google Scholar] [CrossRef] [PubMed]
- Finotelli, P.V.; Da Silva, D.; Sola-Penna, M.; Rossi, A.M.; Farina, M.; Andrade, L.R.; Takeuchi, A.Y.; Rocha-Leão, M.H.; Biointerfaces, S.B. Microcapsules of alginate/chitosan containing magnetic nanoparticles for controlled release of insulin. Colloids Surf. B Biointerfaces 2010, 81, 206–211. [Google Scholar] [CrossRef]
- Morales, E.; Rubilar, M.; Burgos-Díaz, C.; Acevedo, F.; Penning, M.; Shene, C. Alginate/Shellac beads developed by external gelation as a highly efficient model system for oil encapsulation with intestinal delivery. Food Hydrocoll. 2017, 70, 321–328. [Google Scholar] [CrossRef]
- Rao, R.S.; Kumar, C.G.; Prakasham, R.S.; Hobbs, P.J. The Taguchi methodology as a statistical tool for biotechnological applications: A critical appraisal. Biotechnol. J. 2008, 3, 510–523. [Google Scholar] [CrossRef] [PubMed]
- Morales, E.; Burgos-Díaz, C.; Zúñiga, R.N.; Jorkowski, J.; Quilaqueo, M.; Rubilar, M.J. Influence of O/W emulsion interfacial ionic membranes on the encapsulation efficiency and storage stability of powder microencapsulated astaxanthin. Food Bioprod. Process 2021, 126, 143–154. [Google Scholar] [CrossRef]
- White, T.J.; Bruns, T.; Lee, S.; Taylor, J. Amplification and direct sequencing of fungal ribosomal RNA genes for phylogenetics. In PCR Protocols: A Guide to Methods and Applications; Innis, M.A., Gelfrand, D.H., Sninsky, J.J., White, T.J., Eds.; Academic Press: New York, NY, USA, 1990; pp. 315–322. [Google Scholar]
- Ortiz, J.; Dias, N.; Alvarado, R.; Soto, J.; Sanhueza, T.; Rabert, C.; Jorquera, M.; Arriagada, C. N-acyl homoserine lactones (AHLs) type signal molecules produced by rhizobacteria associated with plants that growing in a metal (oids) contaminated soil: A catalyst for plant growth. Microbiol. Res. 2024, 281, 127606. [Google Scholar] [CrossRef]
- Viterbo, A.; Landau, U.; Kim, S.; Chernin, L.; Chet, I. Characterization of ACC deaminase from the biocontrol and plant growth-promoting agent Trichoderma asperellum T203. FEMS Microbiol. Lett. 2010, 305, 42–48. [Google Scholar] [CrossRef]
- Soto, J.; Sanhueza, T.; Ortiz, J.; Luz Mora, M.d.l.; Garcia-Romera, I.; Arriagada, C. Plant growth-promotion and abiotic stress tolerance of dark septate endophyte fungi isolated from roots of native Andean Ericaceae plants colonizing volcanic deposits in southern Chile. J. Soil Sci. Plant Nutr. 2024, 24, 5144–5153. [Google Scholar] [CrossRef]
- Zilda, D.S.; Harmayani, E.; Widada, J.; Asmara, W.; Irianto, H.E.; Patantis, G.; Fawzya, Y.N. Screening of thermostable protease producing microorganisms isolated from Indonesian hot-spring. Squalen Bull. Mar. Fish. Postharvest Biotechnol. 2012, 7, 105–114. [Google Scholar] [CrossRef]
- Kasana, R.C.; Salwan, R.; Dhar, H.; Dutt, S.; Gulati, A. A rapid and easy method for the detection of microbial cellulases on agar plates using gram’s iodine. Curr. Microbiol. 2008, 57, 503–507. [Google Scholar] [CrossRef] [PubMed]
- Kumar, D.; Kumar, L.; Nagar, S.; Raina, C.; Parshad, R.; Gupta, V.K. Screening, isolation and production of lipase/esterase producing Bacillus sp. strain DVL2 and its potential evaluation in esterification and resolution reactions. Arch. Appl. Sci. Res. 2012, 4, 1763–1770. [Google Scholar]
- Fuentes-Quiroz, A.; Herrera, H.; Alvarado, R.; Rabert, C.; Arriagada, C.; Valadares, R. Functional differences of cultivable leaf-associated microorganisms in the native Andean tree Gevuina avellana Mol. (Proteaceae) exposed to atmospheric contamination. J. Appl. Microbiol. 2024, 135, lxae041. [Google Scholar] [CrossRef]
- Morales, E.; Quilaqueo, M.; Morales-Medina, R.; Drusch, S.; Navia, R.; Montillet, A.; Rubilar, M.; Poncelet, D.; Galvez-Jiron, F.; Acevedo, F. Pectin–chitosan hydrogel beads for delivery of functional food ingredients. Foods 2024, 13, 2885. [Google Scholar] [CrossRef]
- Alkhatib, H.; Doolaanea, A.A.; Assadpou, E.; Mohmad Sabere, A.S.; Mohamed, F.; Jafari, S.M. Optimizing the encapsulation of black seed oil into alginate beads by ionic gelation. J. Food Eng. 2022, 328, 111065. [Google Scholar] [CrossRef]
- Naderi, K.; Etesami, H.; Alikhani, H.A.; Arani, A.M. Potential use of endophytic and rhizosheath bacteria from the desert plant Stipagrostis pennata as biostimulant against drought in wheat cultivars. Rhizosphere 2022, 24, 100617. [Google Scholar] [CrossRef]
- Ballesteros, G.I.; Newsham, K.K.; Acuña-Rodríguez, I.S.; Atala, C.; Torres-Díaz, C.; Molina-Montenegro, M.A. Extreme environments as sources of fungal endophytes mitigating climate change impacts on crops in Mediterranean-type ecosystems. Plants People Planet 2024, 6, 148–161. [Google Scholar] [CrossRef]
- Nadeem, S.M.; Ahmad, M.; Tufail, M.A.; Asghar, H.N.; Nazli, F.; Zahir, Z.A. Appraising the potential of EPS-producing rhizobacteria with ACC-deaminase activity to improve growth and physiology of maize under drought stress. Physiol. Plant 2021, 172, 463–476. [Google Scholar] [CrossRef] [PubMed]
- Zhao, B.; Alonso, N.F.; Miras, J.; Vílchez, S.; García-Celma, M.J.; Morral, G.; Esquena, J. Triggered protein release from calcium alginate/chitosan gastro-resistant capsules. Coll. Surf. A Physicochem. Eng. Asp. 2024, 693, 133998. [Google Scholar] [CrossRef]
- Chan, E.-S.; Lee, B.-B.; Ravindra, P.; Poncelet, D.J. Prediction models for shape and size of ca-alginate macrobeads produced through extrusion–dripping method. J. Colloid Interface Sci. 2009, 338, 63–72. [Google Scholar] [CrossRef] [PubMed]
- Athayde, A.J.A.A.; Berger, L.R.R.; de Albuquerque, T.M.R.; Sampaio, K.B.; Fernandes, K.F.D.; do Nascimento, H.M.A.; de Oliveira, S.P.A.; Lopes, L.A.A.; de Oliveira, C.E.V.; da Conceição, M.L.J.P.; et al. Physiological and Technological Properties of Probiotic Lacticaseibacillus rhamnosus GG Encapsulated with Alginate-Chitosan Mixture and Its Incorporation in Whole Milk. Probiotics Antimicrob. Proteins 2024, 1–13. [Google Scholar] [CrossRef]
- Truong, V.; Nguyen, P.T.; Truong, V. The prediction model of nozzle height in liquid jet-drop method to produce Ca-alginate beads under microencapsulation process. J. Food Process Eng. 2021, 44, 13663. [Google Scholar] [CrossRef]
- Thinkohkaew, K.; Aumphaiphensiri, N.; Tangamornsiri, T.; Niamsiri, N.; Potiyaraj, P.; Suppavorasatit, I.F. Inulin extracted from burdock root (Arctium lappa L.) incorporated alginate/chitosan hydrogel beads for probiotics encapsulation. J. Agric. Food Res. 2024, 18, 101405. [Google Scholar] [CrossRef]
- Ali, M.; Cybulska, J.; Frąc, M.; Zdunek, A. Application of polysaccharides for the encapsulation of beneficial microorganisms for agricultural purposes: A review. Int. J. Biol. Macromol. 2023, 244, 125366. [Google Scholar] [CrossRef]

| Design Point | Frequency (Hz) | Distance (cm) | Chitosan (%) | Mean Size (mm) | Sphericity of Capsules |
|---|---|---|---|---|---|
| 1 | 40 | 5 | 1 | 4.91 ± 0.013 | 0.925 ± 0.002 |
| 2 | 40 | 15 | 2 | 3.44 ± 0.002 | 0.902 ± 0.003 |
| 3 | 120 | 5 | 2 | 3.64 ± 0.070 | 0.904 ± 0.004 |
| 4 | 120 | 15 | 1 | 2.17 ± 0.001 | 0.908 ± 0.000 |
| AP a | IAA b | ACC c | SID d | EPS e | P Solubilization f | |||
|---|---|---|---|---|---|---|---|---|
| Ca3(PO4)2 | AlO4P | FeO4P 2H2O | Phytic Acid | |||||
| 40.47 ± 0.9 | 0.94 ± 0.1 | ND | 6.13 ± 0.3 | 102.02 ± 3.1 | 2.6 ± 0.0 | 5.5 ± 0.0 | 5 ± 0.0 | 2.2 ± 0.3 |
Disclaimer/Publisher’s Note: The statements, opinions and data contained in all publications are solely those of the individual author(s) and contributor(s) and not of MDPI and/or the editor(s). MDPI and/or the editor(s) disclaim responsibility for any injury to people or property resulting from any ideas, methods, instructions or products referred to in the content. |
© 2025 by the authors. Licensee MDPI, Basel, Switzerland. This article is an open access article distributed under the terms and conditions of the Creative Commons Attribution (CC BY) license (https://creativecommons.org/licenses/by/4.0/).
Share and Cite
Arriagada-Escamilla, C.; Ortiz, J.; Iturra, N.; Soto, J.; Morales, E. Jet-Breaking Extrusion of Alginate–Chitosan Capsules for Encapsulation of Plant Growth–Promoting Extremophilic Fungi. Microorganisms 2025, 13, 1123. https://doi.org/10.3390/microorganisms13051123
Arriagada-Escamilla C, Ortiz J, Iturra N, Soto J, Morales E. Jet-Breaking Extrusion of Alginate–Chitosan Capsules for Encapsulation of Plant Growth–Promoting Extremophilic Fungi. Microorganisms. 2025; 13(5):1123. https://doi.org/10.3390/microorganisms13051123
Chicago/Turabian StyleArriagada-Escamilla, César, Javier Ortiz, Nicole Iturra, Javiera Soto, and Eduardo Morales. 2025. "Jet-Breaking Extrusion of Alginate–Chitosan Capsules for Encapsulation of Plant Growth–Promoting Extremophilic Fungi" Microorganisms 13, no. 5: 1123. https://doi.org/10.3390/microorganisms13051123
APA StyleArriagada-Escamilla, C., Ortiz, J., Iturra, N., Soto, J., & Morales, E. (2025). Jet-Breaking Extrusion of Alginate–Chitosan Capsules for Encapsulation of Plant Growth–Promoting Extremophilic Fungi. Microorganisms, 13(5), 1123. https://doi.org/10.3390/microorganisms13051123







